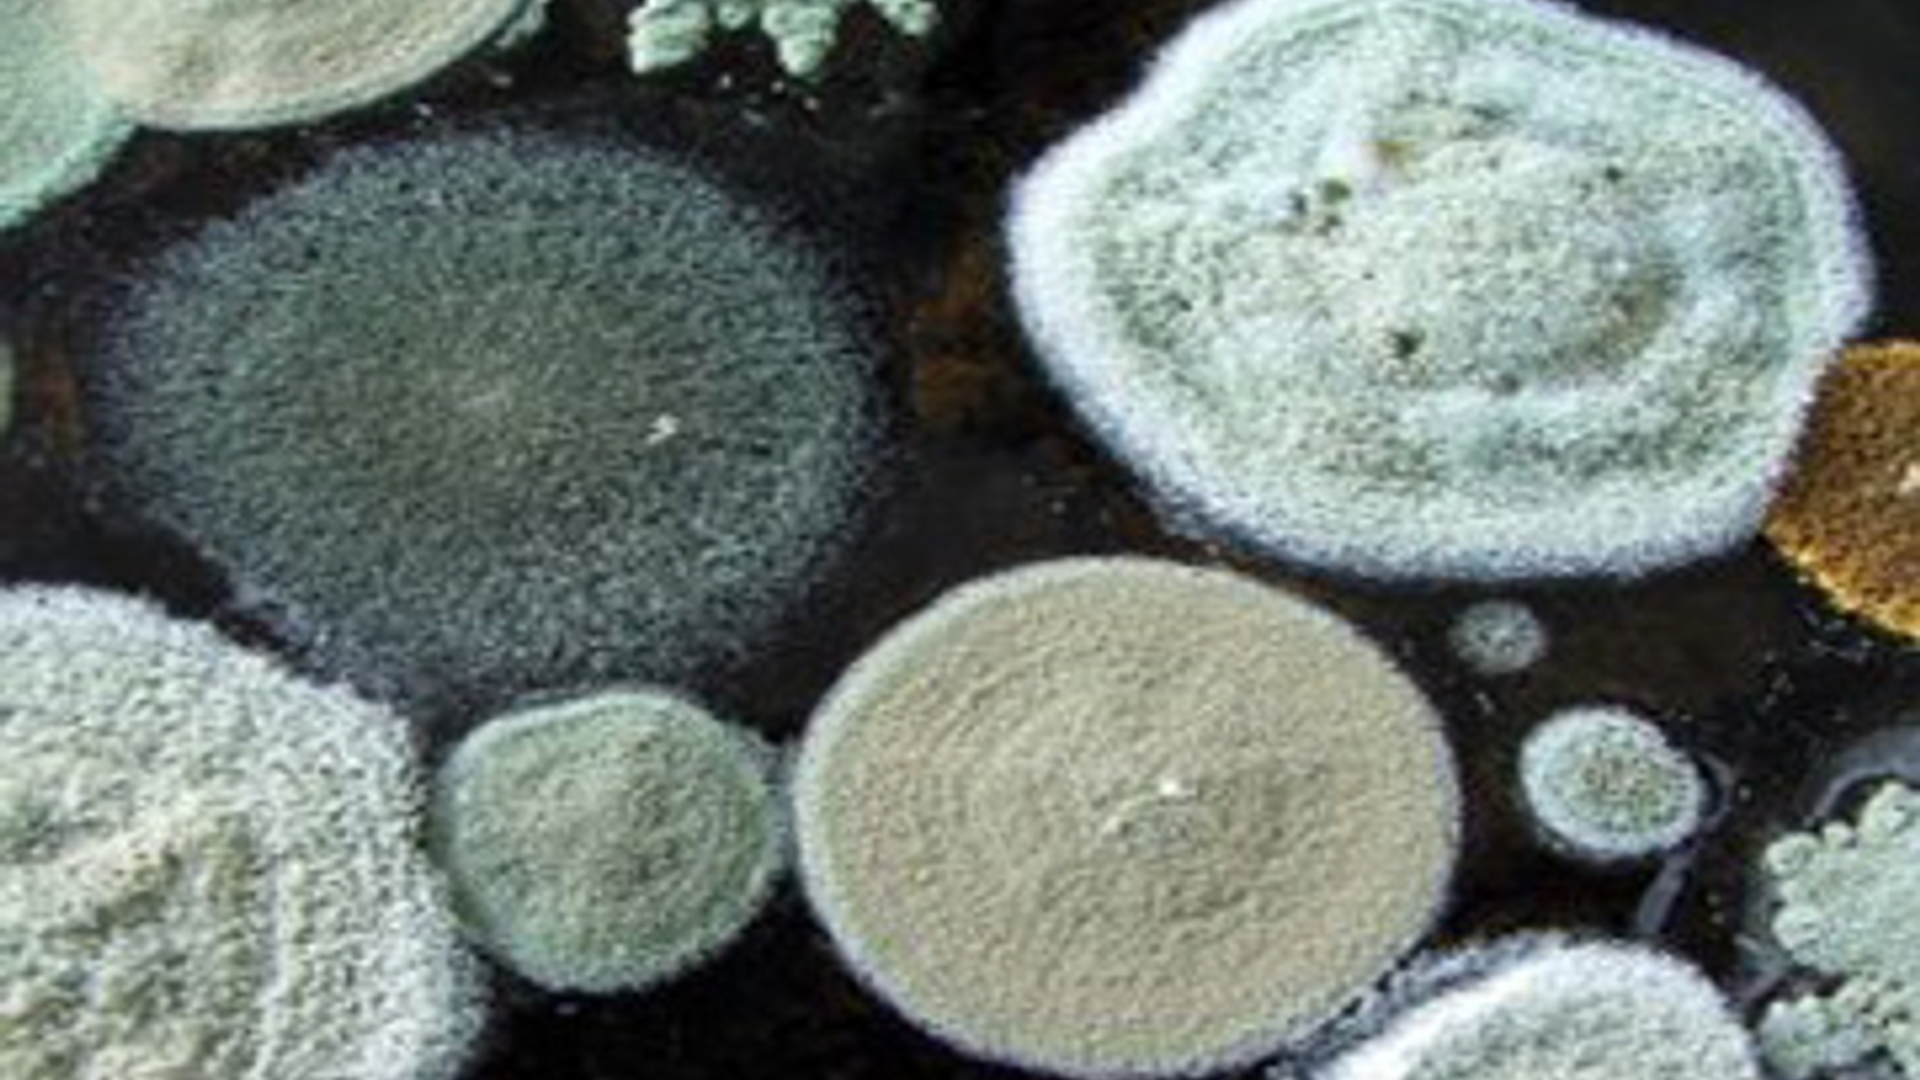
570948_moldy.jpg

Het consumentenplatform van BNNVARA.
Duitse Huurdersbond eist 'schimmelpolitie'
17-08-2010
leestijd 1 minuten
54 keer bekeken
Duitsland moet een schimmelpolitie krijgen. Die moet verhuurders aanspreken op schimmel in woningen, de verwijdering van de zwammen eisen en desnoods boetes opleggen. Dit eist de DMB, de grootste Duitse belangenvereniging van huurders.
Dit heeft Bild, de grootste Duitse krant, dinsdag gemeld. Volgens de DMB is er in naar schatting 3 miljoen woningen in Duitsland sprake van overlast door schimmels. De huurdersbond wijst erop dat schimmels gevaarlijk zijn voor de volksgezondheid. Schimmels gedijen bij te veel vocht in de woning. ,,Veel verhuurders doen niets aan de gebreken. In plaats daarvan verwijten zij de huurders dat zij verkeerd hebben gestookt of geventileerd'', aldus de DMB.
Bron: ANP
Praat mee
Altijd op de hoogte blijven van het laatste nieuws?
Meld je snel en gratis aan voor de Kassa nieuwsbrief!
